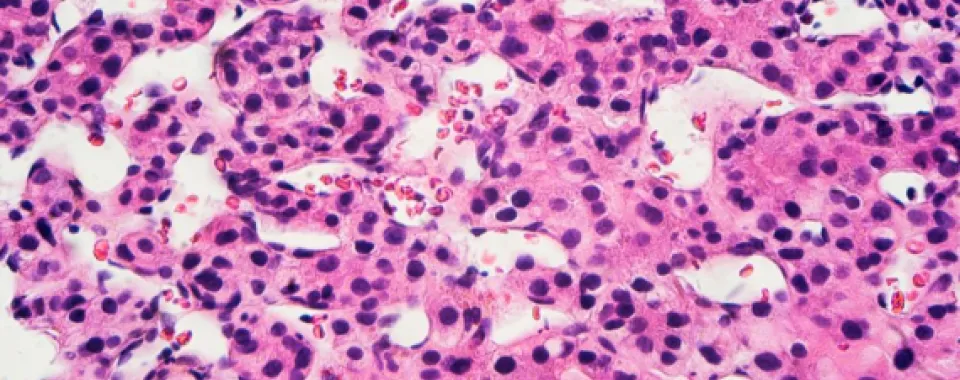
Image par microscopie d’un carcinome hépatocellulaire - Unige.ch

Une méta-analyse menée par une équipe de l’UNIGE et des HUG montre qu’une infection par le virus de l’hépatite D, dont le dépistage est souvent négligé, multiplie par trois le risque de développer un cancer du foie.
Parmi tous les virus de l’hépatite, le D est le plus mal connu. En effet, ce petit virus, qui ne peut infecter que les personnes déjà atteintes par l’hépatite B, n’a jusqu’ici été que peu étudié. Or, l’hépatite D constitue l’une des formes les plus dangereuses d’hépatite virale chronique à cause de son évolution possible vers des affections irréversibles du foie (cancer et cirrhose, notamment). Des scientifiques de l’Université de de Genève (UNIGE) et des Hôpitaux universitaires de Genève (HUG) se sont penchés sur la conséquence la plus grave de l’hépatite chronique: le carcinome hépatocellulaire, un cancer du foie particulièrement agressif et souvent mortel. En menant une revue systématique de la littérature et en effectuant une méta-analyse de toutes les données disponibles, ils démontrent que les personnes infectées par le virus de l’hépatite D ont un risque jusqu’à trois fois plus élevé de développer un carcinome hépatocellulaire que celles infectées uniquement par le virus l’hépatite B. Ces résultats, à lire dans le Journal of Hepatology, plaident pour un dépistage systématique de l’hépatite D chez les patients atteints d’hépatite B afin, d’une part, de mieux prendre en charge les patients, et, de l’autre, de mieux appréhender la prévalence réelle de la maladie.
Il existe cinq types de virus de l’hépatite, aux manifestations et aux conséquences très différentes. Les hépatites A et E causent des infections aigües parfois sévères mais transitoires. Les hépatites B, C et D peuvent, quant à elles, devenir chroniques et engendrer des dysfonctionnements du foie des mois, voire des années après l’infection. Si l’hépatite C est maintenant bien soignée, les hépatites B, et surtout D restent encore difficiles à contrôler. «La conséquence la plus grave des hépatites B et D est le carcinome hépatocellulaire, explique Francesco Negro, professeur au Département de pathologie et immunologie de la Faculté de médecine de l’UNIGE et responsable de l’Unité de viropathologie des HUG. On savait déjà que la co-infection des hépatites B et D accélérait la progression de la cirrhose. On ignore cependant dans quelle mesure la co-infection des hépatites B et D augmente le risque de progression vers le cancer du foie, comme nous savons qu’elle le fait pour la cirrhose.»
«Pour savoir si l’hépatite D est encore plus dangereuse que la B, nous avons effectué une revue systématique et une méta-analyse de toutes les études épidémiologiques», détaille Dulce Alfaiate, chercheuse au Département de pathologie et immunologie de la Faculté de médecine de l’UNIGE et première auteure de ces travaux. «Pour cela, nous avons ré-étudié les données présentées dans 93 études, soit plus de 100 000 patients au total. Toutes ces études ne sont pas de qualité identique mais l’analyse des meilleures d’entre elles est très nette: les patients atteints d’hépatite D ont un risque presque triplé de développer un carcinome hépatocellulaire par rapport à ceux atteints uniquement de l’hépatite B. C’est énorme!»
Au moins 15 millions de personnes infectées dans le monde
Selon les chiffres de l’Organisation mondiale de la santé, l’infection par le virus de l’hépatite B concerne des centaines de millions de personnes. Dans certaines régions, comme en Polynésie et dans certains pays d’Afrique, plus de 6% de la population adulte est infectée et le virus se propage en grande partie de la mère à l’enfant. De plus, les enfants infectés à la naissance développent quasiment systématiquement la forme chronique de la maladie.
Le virus de l’hépatite D infecte à son tour une partie non négligeable des personnes porteuses de l’hépatite B mais on ignore l’ampleur du problème. «Certaines estimations font état de 15 à 20 millions de personnes au moins infectées par l’hépatite D et d’autres de 60 millions, soit presque le double que le nombre de personnes vivant avec le VIH dans le monde, indique Dulce Alfaiate. En l’absence de tests systématiques, cependant, il est extrêmement difficile d’être précis.» En Suisse il y aurait ainsi 25 000 personnes infectées par l’hépatite B, et 1,500 par l’hépatite D. Et ce, malgré un vaccin contre l’hépatite B disponible et efficace.
Un appel à la recherche
A part l’interféron, un antiviral et un immuno-modulateur peu efficace et aux effets secondaires délétères, il n’existe à l’heure actuelle
aucun traitement contre l’hépatite D. «L’évolution de cette maladie vers le cancer du foie nous semble sous-estimée, souligne Francesco Negro. Et pourtant, cette maladie affecte des patients jeunes qui souffrent de cirrhose dès l’âge de 25-30 ans.»
Plusieurs pistes de contrôle de la maladie sont actuellement explorées: le laboratoire de Francesco Negro étudie ainsi les modifications épigénétiques induites par le virus et le mécanisme d’apparition des tumeurs du foie. Et les auteurs de conclure: «Nos travaux soulignent la nécessité d’améliorer le dépistage de l’hépatite D chez les patients atteints d’hépatite B ainsi que le besoin urgent de thérapies antivirales efficaces, comme celle contre l’hépatite C qui a sauvé depuis 2011 la vie de millions de personnes.»
DOI: 10.1016/j.jhep.2020.02.030
Francesco Negro
Professeur ordinaire au Département de pathologie et immunologie - Faculté de médecine
Médecin-adjoint agrégé - Service de gastroentérologie et hépatologie et Service de Pathologie clinique des HUG
Francesco.Negro@unige.ch
+4122 379 58 00